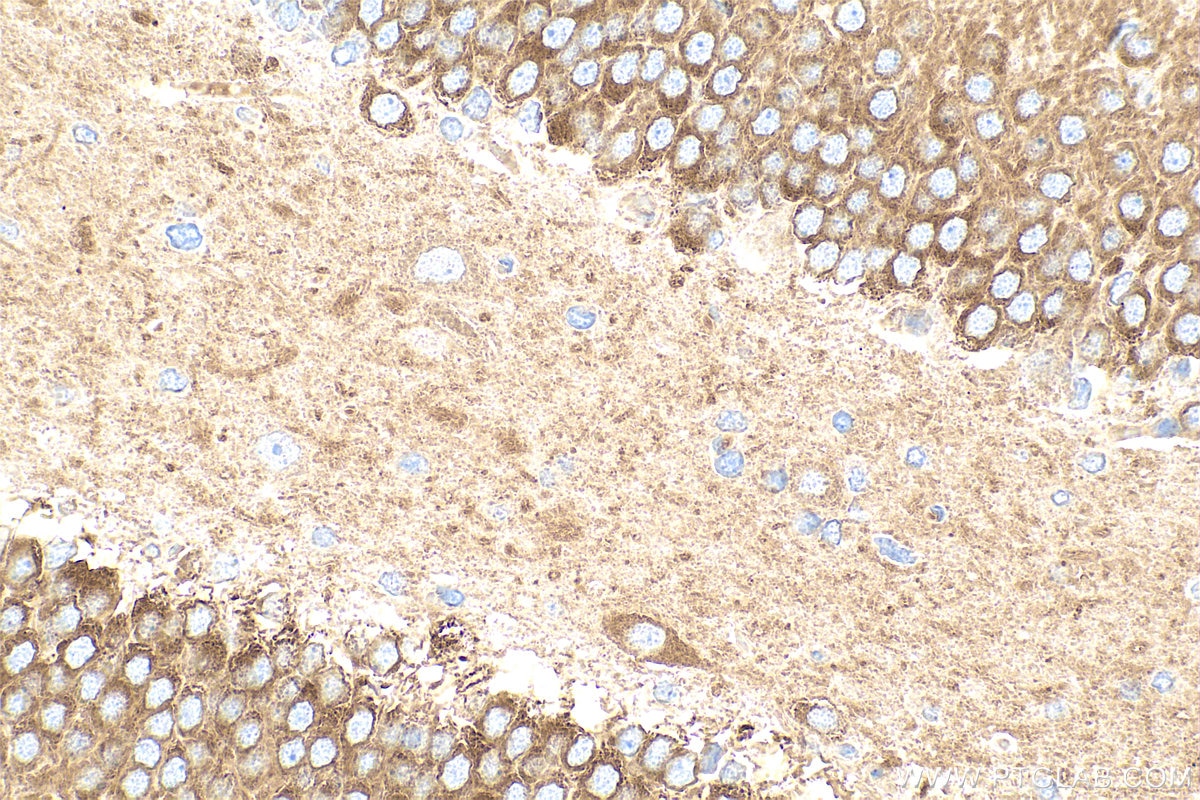
Immunohistochemistry (IHC) staining of rat brain tissue using CAMKV Polyclonal antibody (14788-1-AP)

Tested Applications
| Positive WB detected in | mouse brain tissue, HeLa cells, mouse spleen tissue, PC-3 cells |
| Positive IP detected in | mouse brain tissue |
| Positive IF-P detected in | mouse brain tissue |
Recommended dilution
| Application | Dilution |
|---|---|
| Western Blot (WB) | WB : 1:500-1:2400 |
| Immunoprecipitation (IP) | IP : 0.5-4.0 ug for 1.0-3.0 mg of total protein lysate |
| Immunofluorescence (IF)-P | IF-P : 1:50-1:500 |
| It is recommended that this reagent should be titrated in each testing system to obtain optimal results. | |
| Sample-dependent, Check data in validation data gallery. | |
Published Applications
| WB | See 4 publications below |
| IHC | See 1 publications below |
| IF | See 1 publications below |
Product Information
14788-1-AP targets CAMKV in WB, IHC, IF-P, IP, ELISA applications and shows reactivity with human, mouse, rat samples.
| Tested Reactivity | human, mouse, rat |
| Cited Reactivity | human, mouse, rat |
| Host / Isotype | Rabbit / IgG |
| Class | Polyclonal |
| Type | Antibody |
| Immunogen |
CatNo: Ag6438 Product name: Recombinant human CAMKV protein Source: e coli.-derived, PGEX-4T Tag: GST Domain: 1-285 aa of BC000497 Sequence: MPFGCVTLGDKKNYNQPSEVTDRYDLGQVIKTEEFCEIFRAKDKTTGKLHTCKKFQKRDGRKVRKAAKNEIGILKMVKHPNILQLVDVFVTRKEYFIFLELATGREVFDWILDQGYYSERDTSNVVRQVLEAVAYLHSLKIVHRNLKLENLVYYNRLKNSKIVISDFHLAKLENGLIKEPCGTPEYLAPEVVGRQRYGRPVDCWAIGVIMYILLSGNPPFYEEVEEDDYENHDKNLFRKILAGDYEFDSPYWDDISQAAKDLVTRLMEVEQDQRITAEEAISHEW Predict reactive species |
| Full Name | CaM kinase-like vesicle-associated |
| Calculated Molecular Weight | 54 kDa |
| Observed Molecular Weight | 54-75 kDa |
| GenBank Accession Number | BC000497 |
| Gene Symbol | CAMKV |
| Gene ID (NCBI) | 79012 |
| RRID | AB_2068552 |
| Conjugate | Unconjugated |
| Form | Liquid |
| Purification Method | Antigen affinity purification |
| UNIPROT ID | Q8NCB2 |
| Storage Buffer | PBS with 0.02% sodium azide and 50% glycerol, pH 7.3. |
| Storage Conditions | Store at -20°C. Stable for one year after shipment. Aliquoting is unnecessary for -20oC storage. 20ul sizes contain 0.1% BSA. |
Background Information
CAMKV(CaM kinase-like vesicle-associated protein) is also named as 1G5,VACAMKL and belongs to the CAMK Ser/Thr protein kinase family. The CAMKV protein, which accumulates predominantly during postnatal development, binds to calmodulin in the presence of calcium. It is detected only in the CNS, is absent from cerebellum, but is detected in most other brain regions, especially regions of the cortex. The protein is predominantly detected in association with the plasma membrane of somatic cell and in neurites, both axons and dendrites, and is frequently observed in active zones, usually associated with vesicle-like structures. Its sequence suggests that lG5 may be membrane associated(PMID:8283228).
Protocols
| Product Specific Protocols | |
|---|---|
| IF protocol for CAMKV antibody 14788-1-AP | Download protocol |
| IP protocol for CAMKV antibody 14788-1-AP | Download protocol |
| WB protocol for CAMKV antibody 14788-1-AP | Download protocol |
| Standard Protocols | |
|---|---|
| Click here to view our Standard Protocols |
Publications
| Species | Application | Title |
|---|---|---|
Mol Neurodegener Nuclear speckle specific hnRNP D-like prevents age- and AD-related cognitive decline by modulating RNA splicing. | ||
Mol Oncol Ryanodine receptor 2 promotes colorectal cancer metastasis by the ROS/BACH1 axis | ||
Int J Mol Sci Comparative Hypothalamic Proteomic Analysis Between Diet-Induced Obesity and Diet-Resistant Rats | ||
Ann Neurol Paraneoplastic Calmodulin Kinase-Like Vesicle-Associated Protein (CAMKV) Autoimmune Encephalitis |
Reviews
The reviews below have been submitted by verified Proteintech customers who received an incentive for providing their feedback.
FH María Inmaculada (Verified Customer) (07-15-2022) | I used the antibody for Western Blot and it worked very well. First, we used it at a 1:500 dilution first, but it was super concentrated and obtained unspecific bands. Then, I used it at a 1:2500 dilution and obtained pretty clean bands for the protein. The signal was very intense with my system, so I think I could have even diluted it a bit more.
|